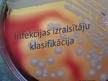
Prezentācija 'Patogēnie koki', 3.

-
Ergonomika
-
Ergonomika
VidusskolaPrezentācija34 -
Gripa
VidusskolaPrezentācija16 -
Patogēnie koki
VidusskolaPrezentācija29
Ergonomika
Faila izmērs:
11415 KB
Identifikators:
1122684